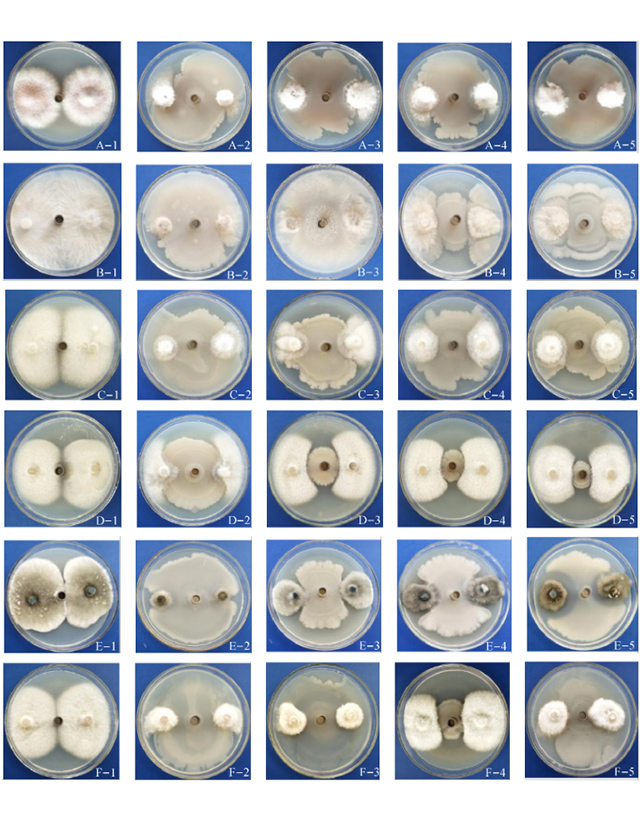

山东元农农业
元农农业-企业介绍

山东元农农业科技有限公司是山东元辰生物医药科技集团有限公司全资子公司,注册资金5,000万;主要业务覆盖微生物菌肥、有机废弃物处理、液体废弃物处理等。公司已与山东省农科院、山东大学生命科学学院等政府高效科研单位建立联合研发及技术应用合作。
企业定位:以技术应用为阵地,销售渠道为核心,服务咨询为特色的销售服务平台
企业愿景:助力绿色生态农业,保卫自然绿水青山
元农农业-菌种库
元农农业保存有抗真菌活性的微生物174株,隶属于13个不同的属、28个种,产品业务包括绿色农业种植、生态养殖、农业环保等。
元农农业-技术应用

绿色农业种植技术
利用微生物技术,提升土壤活力,增强作物抗逆性能,无二次污染,提高作物产量

有机废弃物处理技术
利用原位生态处理方式,实现有机废弃物无害化和资源化处理,变废为宝,使其成为优良的微生物肥料。

污水生物处理技术
利用微生物技术,以低成本投入,制定针对性解决方案,实现液体废弃物高效无害化处理。
元农农业-产品应用

生物有机肥
以生物有机肥为主打的肥料产品体系,涵盖菌剂、菌肥、元素肥、叶面肥等主流产品

微生物菌剂
自制自产枯草、地衣等微生物菌种,适用于种植、家禽水产养殖营养调理剂

有机废弃物一体化解决方案
针对动物粪便、厨余垃圾等有机废弃物发酵、生产于一体的解决方案